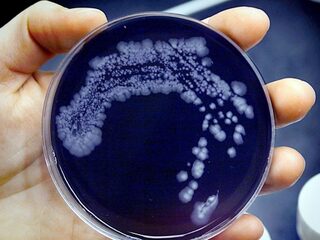
Gaan er straks meer mensen dood aan bacteriën dan aan kanker?

Nieuws
Wetenschap & Techniek
- Nieuws
- Wetenschap & Techniek
- FocusNTR
Muziek als medicijn voor zieke kinderen
- FocusNTR
Hoe kun je je huis het beste duurzaam maken?
- Nieuws en CoNOS/NTR
Hebben we een nieuwe Thatcher nodig om de aarde te redden?
- FocusNTR
InScience-filmfestival in teken van kunstmatige intelligentie
- FocusNTR
Dus jij dacht dat apen elkaar ontvlooien? Lariekoek
- FocusNTR
Een Algorave, wat is dat?
- FocusNTR
Hoe realistisch is Assassin’s Creed Odyssey?
- Nieuws en CoNOS/NTR
Waarom onze manier van praten bijdraagt aan polarisatie
- Nieuws en CoNOS/NTR
Kun je meten hoe bier smaakt?
- Nieuws en CoNOS/NTR
Poep in plaats van slijm: nieuwe tbc-test voor kinderen
- Nieuws en CoNOS/NTR
Heeft het zin om diersoorten te herintroduceren in de natuur?
- FocusNTR
Gaan er straks meer mensen dood aan bacteriën dan aan kanker?